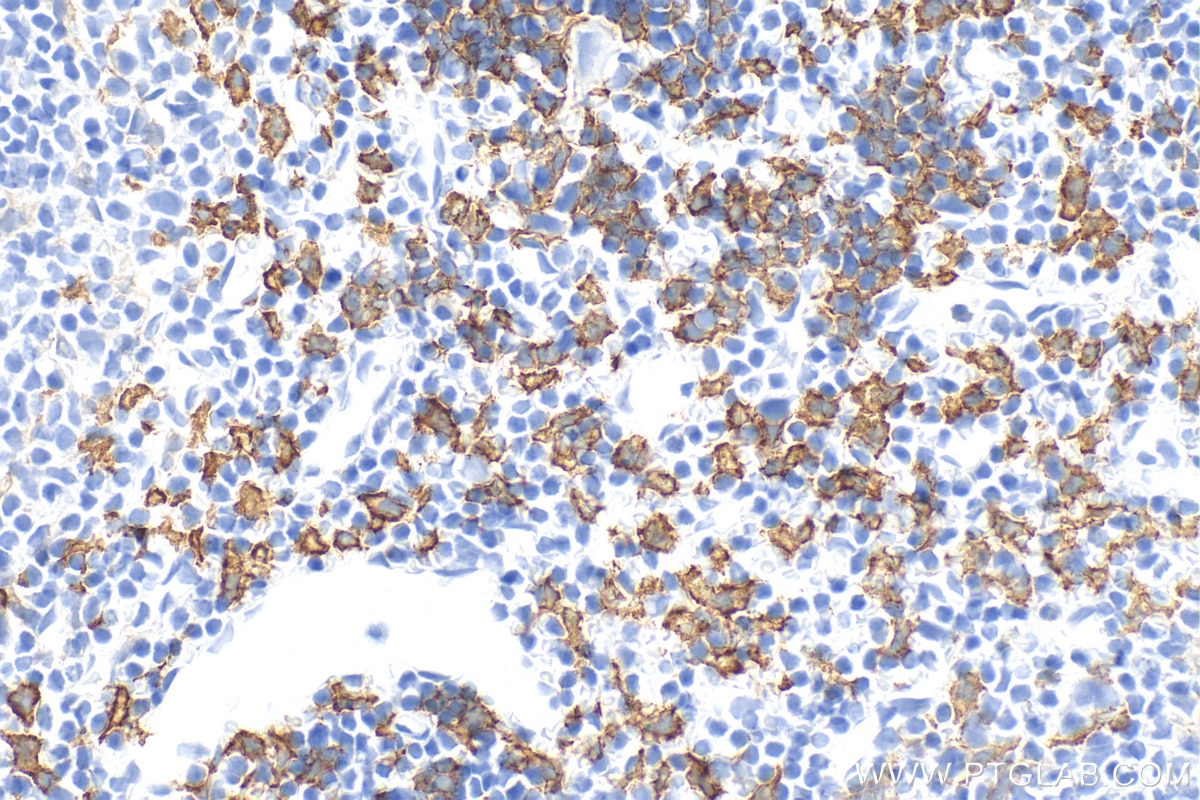
Immunohistochemistry (IHC) staining of mouse spleen tissue using F4/80 Polyclonal antibody (28463-1-AP)

Tested Applications
| Positive WB detected in | unboiled J774A.1 cells, unboiled RAW 264.7 cells |
| Positive IHC detected in | mouse spleen tissue, rat spleen tissue, rat liver tissue, mouse lung tissue, mouse heart tissue, mouse brain tissue, mouse liver tissue, mouse small intestine tissue Note: suggested antigen retrieval with TE buffer pH 9.0; (*) Alternatively, antigen retrieval may be performed with citrate buffer pH 6.0 |
| Positive IF-P detected in | mouse spleen tissue, mouse liver tissue |
| Positive IF-Fro detected in | mouse spleen tissue |
| Positive IF/ICC detected in | RAW 264.7 cells |
Recommended dilution
| Application | Dilution |
|---|---|
| Western Blot (WB) | WB : 1:1000-1:4000 |
| Immunohistochemistry (IHC) | IHC : 1:4000-1:16000 |
| Immunofluorescence (IF)-P | IF-P : 1:50-1:500 |
| Immunofluorescence (IF)-FRO | IF-FRO : 1:50-1:500 |
| Immunofluorescence (IF)/ICC | IF/ICC : 1:200-1:800 |
| It is recommended that this reagent should be titrated in each testing system to obtain optimal results. | |
| Sample-dependent, Check data in validation data gallery. | |
Published Applications
| WB | See 21 publications below |
| IHC | See 163 publications below |
| IF | See 153 publications below |
Product Information
28463-1-AP targets F4/80 in WB, IHC, IF/ICC, IF-P, IF-Fro, ELISA applications and shows reactivity with mouse, rat samples.
| Tested Reactivity | mouse, rat |
| Cited Reactivity | human, mouse, rat, pig |
| Host / Isotype | Rabbit / IgG |
| Class | Polyclonal |
| Type | Antibody |
| Immunogen |
CatNo: Ag28252 Product name: Recombinant mouse Adgre1 protein Source: e coli.-derived, PGEX-4T Tag: GST Domain: 443-644 aa of NM_010130 Sequence: MELSKEETSTLGTILLETVESTMLAALLIPSGNASQMIQTEYLDIESKVINEECKENESINLAARGDKMNVGCFIIKESVSTGAPGVAFVSFAHMESVLNERFFEDGQSFRKLRMNSRVVGGTVTGEKKEDFSKPIIYTLQHIQPKQKSERPICVSWNTDVEDGRWTPSGCEIVEASETHTVCSCNRMANLAIIMASGELTME Predict reactive species |
| Full Name | EGF-like module containing, mucin-like, hormone receptor-like sequence 1 |
| Calculated Molecular Weight | 102 kDa |
| Observed Molecular Weight | 130 kDa, 160 kDa |
| GenBank Accession Number | NM_010130 |
| Gene Symbol | F4/80 |
| Gene ID (NCBI) | 13733 |
| RRID | AB_2881149 |
| Conjugate | Unconjugated |
| Form | Liquid |
| Purification Method | Antigen affinity purification |
| UNIPROT ID | Q61549 |
| Storage Buffer | PBS with 0.02% sodium azide and 50% glycerol, pH 7.3. |
| Storage Conditions | Store at -20°C. Stable for one year after shipment. Aliquoting is unnecessary for -20oC storage. 20ul sizes contain 0.1% BSA. |
Background Information
Mouse F4/80, also named as EMR1 and Gpf480, is a 160-kDa cell surface glycoprotein which is a member of the EGF TM7 family. The F4/80 molecule is solely expressed on the surface of macrophages and serves as a marker for mature macrophage tissues, including Kupffer cells in liver, splenic red pulp macrophages, brain microglia, gut lamina propria and Langerhans cells in the skin. The function of F4/80 is unclear, but it is speculated to be involved in macrophage adhesion events, cell migration or as a G protein-coupled signaling component of macrophages.
Protocols
| Product Specific Protocols | |
|---|---|
| IF protocol for F4/80 antibody 28463-1-AP | Download protocol |
| IHC protocol for F4/80 antibody 28463-1-AP | Download protocol |
| WB protocol for F4/80 antibody 28463-1-AP | Download protocol |
| Standard Protocols | |
|---|---|
| Click here to view our Standard Protocols |
Publications
| Species | Application | Title |
|---|---|---|
Bioact Mater Profibrogenic macrophage-targeted delivery of mitochondrial protector via exosome formula for alleviating pulmonary fibrosis | ||
Nat Commun Dubosiella newyorkensis modulates immune tolerance in colitis via the L-lysine-activated AhR-IDO1-Kyn pathway | ||
Nat Commun Selectively targeting the AdipoR2-CaM-CaMKII-NOS3 axis by SCM-198 as a rapid-acting therapy for advanced acute liver failure | ||
Nat Commun Near-infrared light-driven metabolic reprogramming of synoviocytes for the treatment of rheumatoid arthritis | ||
Adv Sci (Weinh) Hierarchical Targeting Nanodrug with Holistic DNA Protection for Effective Treatment of Acute Kidney Injury |
Reviews
The reviews below have been submitted by verified Proteintech customers who received an incentive for providing their feedback.
FH Lucia (Verified Customer) (04-08-2026) | Worked perfectly on liver, spleen and lung, but could not get a good staining on the heart. Tried multiple concentrations from 1:500 to 1:8000.
|
FH Kannan (Verified Customer) (06-13-2023) | AR using EDTApH9. overnight incubation of primary antibody at 4c.
|